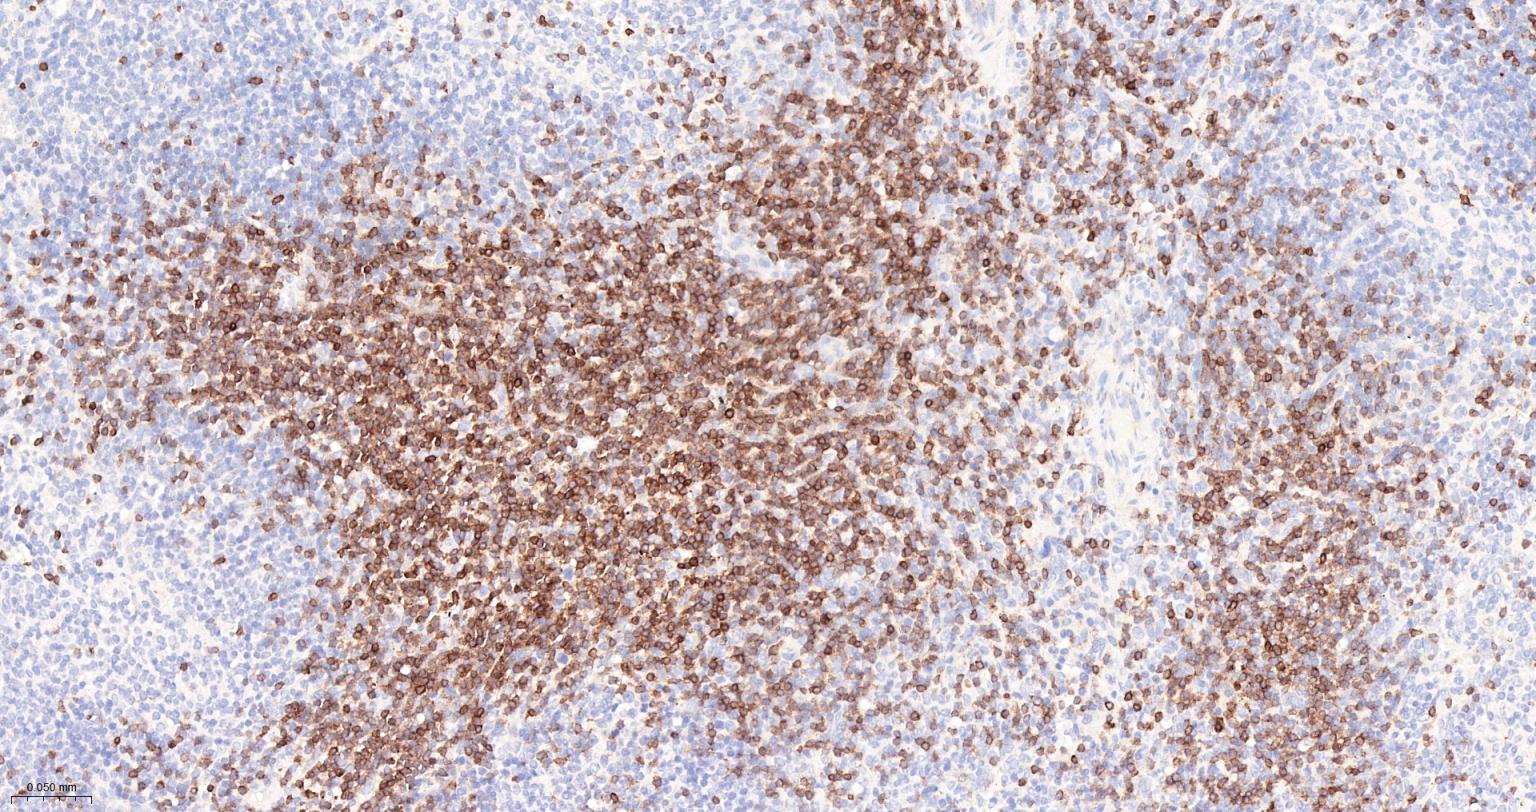
CD3G重组兔单抗-bsm-54300R

CD3 gamma Recombinant Rabbit mAb (一抗) - WB,IHC-P,IHC-F,IF,Flow-Cyt,ICC/IF | Bioss
Rrmab?兔单抗

货号:bsm-54300R
产品详情
相关标记
相关产品
相关文献
常见问题
概述
产品编号
bsm-54300R
产品类型
重组兔单抗、mIHC精品抗体
英文名称
CD3 gamma Recombinant Rabbit mAb
中文名称
CD3G重组兔单抗
英文别名
CD3-GAMMA; CD3GAMMA; IMD17; T3G; Ctg-3; Ctg3; CD3G; CD3G_BOVIN; T-cell receptor T3 gamma chain; CD3G_HUMAN; CD3G_MOUSE; CD3G_PIG; CD3G_RAT; CD3G_SHEEP;
抗体来源
Rabbit
免疫原
KLH conjugated synthetic peptide derived from human CD3 gamma
亚型
IgG
性状
Liquid
纯化方法
affinity purified by Protein A
克隆类型
Recombinant
克隆号
2B11
理论分子量
20 kDa
检测分子量
17-23 kDa
浓度
1mg/ml
储存液
0.01M TBS (pH7.4) with 1% BSA, 0.02% Proclin300 and 50% Glycerol.
研究领域
Immunology > Adaptive Immunity > T Cells > CD
SWISS
Gene ID
保存条件
Shipped at 4℃. Store at -20℃ for one year. Avoid repeated freeze/thaw cycles.
注意事项
This product as supplied is intended for research use only, not for use in human, therapeutic or diagnostic applications.
数据库链接
背景资料
The protein encoded by this gene is the CD3-gamma polypeptide, which together with CD3-epsilon, -delta and -zeta, and the T-cell receptor alpha/beta and gamma/delta heterodimers, forms the T-cell receptor-CD3 complex. This complex plays an important role in coupling antigen recognition to several intracellular signal-transduction pathways. The genes encoding the epsilon, gamma and delta polypeptides are located in the same cluster on chromosome 11. Defects in this gene are associated with T cell immunodeficiency. [provided by RefSeq, Jul 2008]

产品应用
| 应用 | 已检合格种属 | 预测种属 | 推荐稀释比例 |
|---|---|---|---|
| WB | Human | Mouse | 1:500-2000 |
| IHC-P | Human, Mouse | 1:100-500 | |
| IHC-F | Human, Mouse | 1:50-200 | |
| IF | Human, Mouse | 1:100-500 | |
| Flow-Cyt | Human, Mouse | 1:50-200 | |
| ICC/IF | Human, Mouse | 1:50-200 |
交叉反应
交叉反应: Human, Mouse
相关产品
暂无相关产品
靶标
基因名
CD3G
蛋白名
T-cell surface glycoprotein CD3 gamma chain
亚细胞定位
membrane
翻译后修饰
Phosphorylated on Tyr residues after T-cell receptor triggering by LCK in association with CD4/CD8 (PubMed:2470098). Phosphorylated also by PKC; leading to the TCR complex down-regulation (PubMed:8187769).
相似性
Contains 1 Ig-like (immunoglobulin-like) domain.
Contains 1 ITAM domain.
Contains 1 ITAM domain.
功能
Part of the TCR-CD3 complex present on T-lymphocyte cell surface that plays an essential role in adaptive immune response. When antigen presenting cells (APCs) activate T-cell receptor (TCR), TCR-mediated signals are transmitted across the cell membrane by the CD3 chains CD3D, CD3E, CD3G and CD3Z. All CD3 chains contain immunoreceptor tyrosine-based activation motifs (ITAMs) in their cytoplasmic domain. Upon TCR engagement, these motifs become phosphorylated by Src family protein tyrosine kinases LCK and FYN, resulting in the activation of downstream signaling pathways (PubMed:2470098). In addition to this role of signal transduction in T-cell activation, CD3G plays an essential role in the dynamic regulation of TCR expression at the cell surface (PubMed:8187769). Indeed, constitutive TCR cycling is dependent on the di-leucine-based (diL) receptor-sorting motif present in CD3G.
同靶标产品
相关文献
提示: 发表研究结果有使用 bsm-54300R 时请让我们知道,以便我们可以引用参考文章。作为回馈,资料提供者将获得我们送上的小礼品。
具体参考文献:bsm-54300R 被引用于1文献中